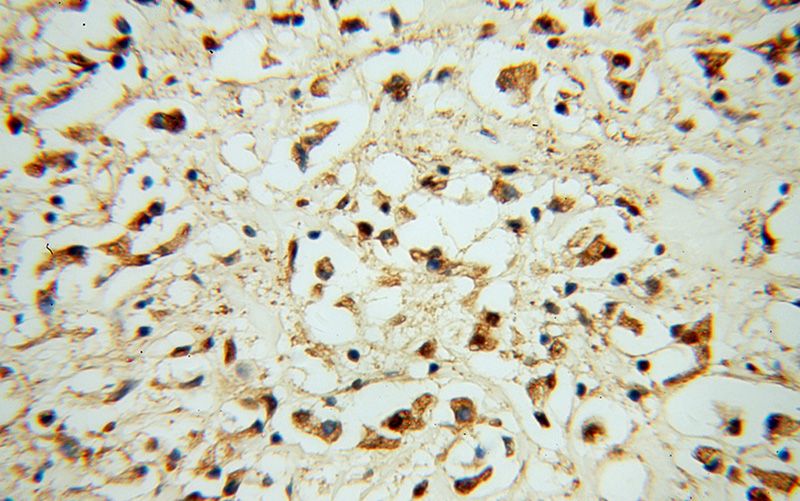
Immunohistochemical of paraffin-embedded human breast cancer using Catalog No:114955(S100A11 antibody) at dilution of 1:50 (under 40x lens)

-
Product Name
S100A11 antibody
- Documents
-
Description
S100A11 Rabbit Polyclonal antibody. Positive IP detected in PC-3 cells. Positive WB detected in PC-3 cells, COLO 320 cells, DU 145 cells, HEK-293 cells, human heart tissue, human lung tissue. Positive IHC detected in human breast cancer tissue, human colon cancer tissue. Positive FC detected in MCF-7 cells. Observed molecular weight by Western-blot: 12 kDa
-
Tested applications
ELISA, IHC, IP, FC, WB
-
Species reactivity
Human,Mouse,Rat; other species not tested.
-
Alternative names
Calgizzarin antibody; MLN 70 antibody; MLN70 antibody; Protein S100 A11 antibody; Protein S100 C antibody; S100A11 antibody; S100C antibody
-
Isotype
Rabbit IgG
-
Preparation
This antibody was obtained by immunization of S100A11 recombinant protein (Accession Number: NM_005620). Purification method: Antigen affinity purified.
-
Clonality
Polyclonal
-
Formulation
PBS with 0.1% sodium azide and 50% glycerol pH 7.3.
-
Storage instructions
Store at -20℃. DO NOT ALIQUOT
-
Applications
Recommended Dilution:
WB: 1:1000-1:10000
IP: 1:500-1:5000
IHC: 1:20-1:200
-
Validations

PC-3 cells were subjected to SDS PAGE followed by western blot with Catalog No:114955(S100A11 antibody) at dilution of 1:2000

WB result of S100A11 antibody (Catalog No:114955, 1:4000) with si-control and si-S100A11 transfected PC-3 cells.

IP Result of anti-S100A11 (IP:Catalog No:114955, 3ug; Detection:Catalog No:114955 1:1000) with PC-3 cells lysate 1000ug.

Immunohistochemical of paraffin-embedded human breast cancer using Catalog No:114955(S100A11 antibody) at dilution of 1:50 (under 10x lens)
Immunohistochemical of paraffin-embedded human breast cancer using Catalog No:114955(S100A11 antibody) at dilution of 1:50 (under 40x lens)

1X10^6 MCF-7 cells were stained with 0.2ug S100A11 antibody (Catalog No:114955, red) and control antibody (blue). Fixed with 90% MeOH blocked with 3% BSA (30 min). Alexa Fluor 488-congugated AffiniPure Goat Anti-Rabbit IgG(H+L) with dilution 1:1000.
-
Background
S100A11 (also known as S100C or calziggarin), is a member of the S100 family of proteins containing 2 EF-hand calcium-binding motifs (PMID: 18694925). S100 proteins are localized in the cytoplasm and/or nucleus of a wide range of cells, and involved in the regulation of a number of cellular processes such as cell cycle progression and differentiation. First discovered in 1989, S100A11 has since been proposed to have direct biological functions in an assortment of physiological processes such as endo- and exocytosis, regulation of enzyme activity, cell growth and regulation, apoptosis and inflammation (PMID: 15241500). Chromosomal rearrangements and altered expression of S100A11 have been implicated in tumor metastasis. This S100A11 antibody (10237-1-AP) has also been instrumental in investigations into S100A11’s role in the development of brain tumors in tuberous sclerosis complex (TSC) patients (PMID: 20133820).
-
References
- Jung MJ, Murzik U, Wehder L, Hemmerich P, Melle C. Regulation of cellular actin architecture by S100A10. Experimental cell research. 316(7):1234-40. 2010.
- Murzik U, Hemmerich P, Weidtkamp-Peters S. Rad54B targeting to DNA double-strand break repair sites requires complex formation with S100A11. Molecular biology of the cell. 19(7):2926-35. 2008.
- Melle C, Ernst G, Schimmel B, Bleul A, von Eggeling F. Colon-derived liver metastasis, colorectal carcinoma, and hepatocellular carcinoma can be discriminated by the Ca(2+)-binding proteins S100A6 and S100A11. PloS one. 3(12):e3767. 2008.
- Chen JH, Ni RZ, Xiao MB, Guo JG, Zhou JW. Comparative proteomic analysis of differentially expressed proteins in human pancreatic cancer tissue. Hepatobiliary & pancreatic diseases international : HBPD INT. 8(2):193-200. 2009.
- Tyburczy ME, Kotulska K, Pokarowski P. Novel proteins regulated by mTOR in subependymal giant cell astrocytomas of patients with tuberous sclerosis complex and new therapeutic implications. The American journal of pathology. 176(4):1878-90. 2010.
- Howell MD, Fairchild HR, Kim BE. Th2 cytokines act on S100/A11 to downregulate keratinocyte differentiation. The Journal of investigative dermatology. 128(9):2248-58. 2008.
- Wang G, Wang X, Wang S. Colorectal cancer progression correlates with upregulation of S100A11 expression in tumor tissues. International journal of colorectal disease. 23(7):675-82. 2008.
- Fan C, Fu Z, Su Q, Angelini DJ, Van Eyk J, Johns RA. S100A11 mediates hypoxia-induced mitogenic factor (HIMF)-induced smooth muscle cell migration, vesicular exocytosis, and nuclear activation. Molecular & cellular proteomics : MCP. 10(3):M110.000901. 2011.
Related Products / Services
Please note: All products are "FOR RESEARCH USE ONLY AND ARE NOT INTENDED FOR DIAGNOSTIC OR THERAPEUTIC USE"
